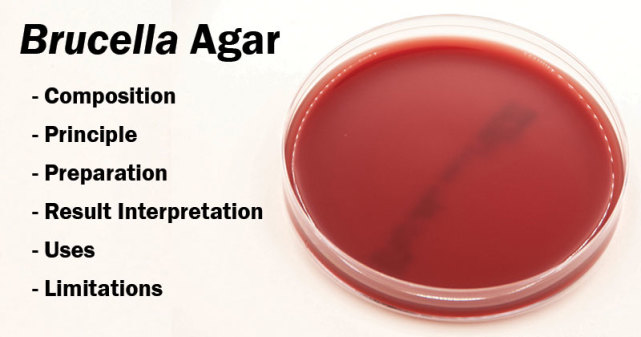

马上注册,结交更多好友,享用更多功能,让你轻松玩转社区。
您需要 登录 才可以下载或查看,没有账号?立即注册

×
转载自:微生物大讲堂
布鲁氏菌(简称布病)是由布鲁氏菌引起的人畜共患传染病,也称波状热。1886 年英国军医 Bruce 在马尔他岛从死于马尔他热的士兵脾脏中分离出布鲁氏菌,首次明确了导致该病的病原体。

布鲁氏菌为革兰氏阴性球状、球杆状细菌,菌体长 0.6~1.5 μm,宽 0.5~0.7 μm,不形成芽孢和荚膜,无鞭毛,不运动,需氧,对营养要求较高,其培养特点是生长繁殖缓慢,牛种布鲁氏菌的培养可在需氧条件下进行。

病菌主要存在于病畜的生殖器官、内脏和血液中。该菌对外界的抵抗力很强,在干燥的土壤中可存活37 d,在冷暗处和胎儿体内可存活 6 个月。

已发现马尔他布鲁氏菌、流产布鲁氏菌、猪布鲁氏菌、绵羊布鲁氏菌、沙林鼠布鲁氏菌和犬布鲁氏菌共 6 个种。
布鲁氏菌病在家畜中,以牛、羊、猪易感。本病主要引起母畜流产,公畜出现睾丸炎。人感染本病后,长期发热、多 汗,出现关节炎、睾丸炎、附睾炎,孕妇可流产等。

布病的传染源主要是病畜及带菌动物,一般羊为主要传染源,其次为牛、猪。

对人的传染途径: 1.直接接触传播 人在饲养、挤奶、剪毛,屠宰及加工皮、毛、肉等过程中,可因接触病畜或其排泄物、分泌物等而被 感染。 2.消化道传播 人进食未消毒的被污染牛奶、奶酪,未熟的动物肉和内脏均可被感染。 3.呼吸道传播 人吸入含布鲁氏菌的尘粒可被感染。 4.其他传播途径 病菌可通过母乳传染给婴儿;患布病动物的排泄物(粪、尿)和分泌物可污染水源,被污染的水源也 可传播布病。
防控手段: 1.疫苗免疫 阴性畜用布鲁氏菌苗免疫。

2.污染场地消毒 被流产胎儿和羊水污染的场地用 10%~20%石灰乳或 10%~20%漂白粉消毒。 被流产物污染的衣物和其他物品用 1%~3% 来苏尔溶液,1%~3%漂白粉上清液或 0.3%新洁儿灭溶液或 0.1%~0. 4%二氯异氰脲酸钠水剂等消毒。 用7.5%的过氧化氢溶液空间消毒。 3.加强家畜管理 管理好家畜要做到如下三点:家畜圈养,统一放牧;人畜分居,牲畜不要饲养在室内;建产羔室,在室内产羔接羔,产羔室内应备防护服、消毒液、肥皂、面盆、毛巾等。

4.做好个人防护 密切接触布病畜的人员包括诊断、采样、扑杀、无害化处理人员及清洗消毒人员、饲养人员等。 5.六步洗手法 用流动的水将双手充分浸湿后,用肥皂或皂液涂抹手掌、手背、手指和指缝,并搓揉双手。

相关链接:布鲁氏菌病的经方临床治验
| 


 窥视卡
窥视卡
 发表于 2019-12-19 19:56:57
发表于 2019-12-19 19:56:57

 提升卡
提升卡 置顶卡
置顶卡 沉默卡
沉默卡